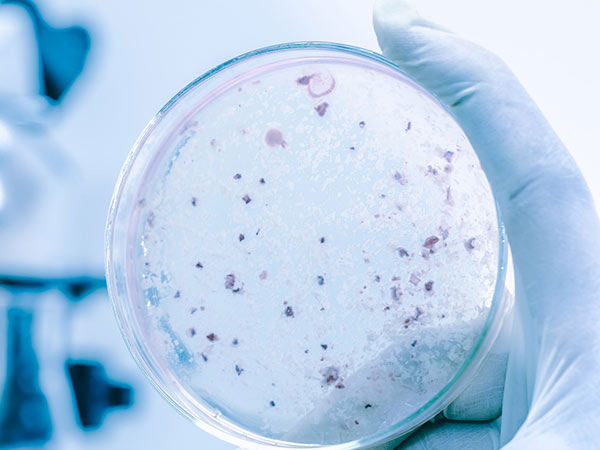

Come prevenire la legionella
Trattamento antilegionella per impianti idrici
Ags Impianti Srl si è specializzata anche nella valutazione del rischio antilegionella, con l’esecuzione di uno speciale trattamento per la disinfezione dell’acqua fredda presente nei condizionatori e risanamenti di impianti idrici.
I trattamenti di depurazione dell’acqua vengono eseguiti per venire incontro alla sempre più crescente esigenza di sicurezza dei cittadini e scongiurare, così, infezioni di varia natura. I nostri tecnici analizzano, prima di tutto, l’impianto idrico e in seguito individuano il trattamento più corretto per la sanificazione degli impianti stessi, tenendo in considerazione i seguenti fattori:
- tipologia di impianto;
- materiali componenti l’impianto;
- presenza di incrostazioni, corrosioni, biofilm;
- grado di contaminazione dell’impianto;
- possibilità di formazione sottoprodotti di disinfezione;
- semplicità di impiego e monitoraggio;
- costo costi di gestione.
L’intervento della nostra azienda sarà volto a valutare il livello di rischio specifico dell’impianto da trattare, individuando tutte le singole fonti di rischio e il metodo più idoneo per la gestione del caso, decidendo il trattamento antilegionella adeguato e prevedendo un piano di manutenzione ordinaria che comprende una serie di controlli analitici.
Le tecnologie da noi impiegate sono in grado di eliminare gradualmente la presenza della legionella abbattendone la carica batterica ed eliminando il biofilm che ne è la fonte primaria, il tutto nel rispetto dell’integrità degli impianti.
Desideri richiedere informazioni più dettagliate? Non esitare a contattarci! Siamo operativi tra i comuni di Brescia, Desenzano del Garda e limitrofi.

Legionella: cos’è, cause e rischi
La legionellosi è un’infezione polmonare molto pericolosa per la salute umana, causata da un batterio chiamato Legionella, appunto, che prolifera negli impianti idrici interni agli edifici.
Si può riscontrare la presenza della legionella nell’acqua sanitaria, calda e fredda, nei condensatori, negli impianti di umificazione, nelle piscine e all’interno dei tubi degli impianti antincendio.
Il batterio della Legionella è molto resistente al cloro e al bromo, può sopravvivere fino a 55°C sia in ambienti alcalini che acidi, con valori di Ph compresi tra 5.5 e 8.1. La legionellosi si può manifestare sia in forma di polmonite, sia in forma febbrile extra polmonare.
Per evitare l’instaurarsi delle condizioni favorenti la moltiplicazione del batterio della Legionella, è necessario vigilare affinché non si verifichino:
- stagnazione delle acque;
- presenza di incrostamenti e sedimenti;
- biofilm nelle tubazioni.
Il rischio di contrarre la malattia dipende anche dalla suscettibilità individuale del soggetto esposto, ovviamente. Per questo motivo sono considerati particolarmente a rischio gli ambienti ospedalieri.
Le patologie possono invece insorgere soltanto quando il batterio prolifera e si porta a concentrazioni elevate in sistemi idrici artificiali che non siano adeguatamente progettati, realizzati e mantenuti.
Per garantire sempre acqua sana e pulita
L’impianto idrico di una struttura è quello più importante da monitorare per assicurare sempre una fonte di acqua sana e pulita. Per questo motivo è necessario predisporre adeguati piani di controllo e analisi, nonché le adeguate attività di sanificazione dell’impianto idrico.
Garantire una fonte di acqua sana è un aspetto fondamentale, soprattutto quando può mettere a serio rischio la salute delle persone che in un modo o in un altro la utilizzano tutti i giorni. La sanificazione di un impianto idrico consiste in una serie di interventi specifici effettuati da personale specializzato e può avvenire con interventi di tipo fisico o di tipo chimico.
Quando viene riscontrata la presenza di batteri Legionella nell’impianto idrico, per prima cosa bisogna sottoporre l’impianto a un trattamento shock per eliminare gli agenti patogeni e ripristinare nell’immediato le funzionalità e la sicurezza dell’impianto. Questi interventi shock sono solitamente preceduti da attività di pulizia di specifiche parti dell’impianto.



Contatta la nostra azienda per saperne di più in merito o per richiedere i trattamenti antilegionella per la depurazione degli impianti! Siamo attivi a Brescia, dove abbiamo sede, Desenzano del Garda e comuni vicini.